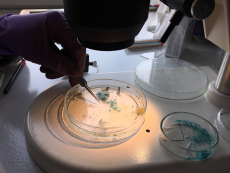

Microplastics in marine habitats
contact: Alexander Tagg

Background
A notable part of plastic waste ends up in the global oceans, e.g. estimated for the year 2010 to amount to 4.8 – 12.7 million metric tons (Jambeck et al., 2015). Plastics have been detected everywhere in the marine system, with particular high accumulation rates in the ocean gyres (Cozar et al., 2014). Our research focuses on microplastics (particles <5mm). Primary microplastics refer to microplastics directly manufactured within this size range, and can be found in consumer care products or as virgin pre-production resin pellets. Secondary microplastics are formed by the fragmentation of larger plastic items, and include clothing fibres and paint flakes.
It is known that microplastics enter the marine system primarily through sewage treatment plants, particularly storm overflow, although other sources, such as industrial spillage, play a role. The consequences of this pollution for the marine food web, however, is not yet understood. In particular, the role of microbial communities, which colonize microplastics, is an important area for further study. First studies on the topic suggest microplastics in the ocean to be colonized by diverse prokaryotic and eukaryotic microorganisms (Zettler et al., 2013, Oberbeckmann et al., 2014). In this context, bacteria of the genus Vibrio deserve special attention. This group of microorganisms harbours several pathogenic species and is further known to associate with biota and form biofilms on marine surfaces. Vibrio bacteria already have been found on plastics in seawater and at beaches (Zettler et al., 2013, Quilliam et al., 2014).

Microplastic research at IOW
Since 2014, research on microplastics in marine habitats has become a particular focus for our research. Our projects cover a very broad range of environments from agricultural land, coastal areas to sea, and from the water surface to the water column and into the sediment.
With our research we aim to i) determine the abundances, sources and sinks of microplastics in the marine system, ii) unravel the diversity and structure of microbial communities associated with microplastics, iii) explore the potential of microplastics to serve as vector for pathogenic bacteria and iv) determine how microplastic paint particles can affect microbial-mediated biogeochemical cycles in sediments and model pollution levels based on 16S data.
Microplastics research in the working group Environmental Microbiology began with the Leibniz-funded project MikrOMIK. This project investigated biofilm communities on microplastics in the Baltic Sea, with additional sampling by the MS Merian in the Sargasso Sea.. In the PlasticSchool project, the findings were transformed into comprehensible and pedagogically valuable school modules. The resulting teaching units can be carried out independently by teachers and are available for all grades.
Since 2017, further microplastic projects have been completed. These projects have primarily focused on the sources and sinks of microplastics in the Baltic Sea and its catchment area. In the MicroCatch_Balt project, the input of microplastics from the river Warnow catchment area into the Baltic Sea was investigated.

BONUS MICROPOLL sampled microplastic presence across the Baltic sea, including associated pollutants and microbial-associations. In the frame of these projects, IOW research was particularly focused on a) microplastic abundance and composition in water, sediments and beaches of the Baltic Sea, b) the retention time and transport of microplastics within the Warnow estuary, and c) the vector function of microplastics for microorganisms. Microplastic presence in agricultural soils was also invested in detail, with a particular focus on inputs from the application of sewage sludge. In the PLASTRAT project, the IOW investigated the levels and dynamics of microplastic within sewage treatment plants, including sewage sludge. The results of these projects will help to fill relevant gaps in the literature and provide reliable information on land-based sources of plastics.
In order to be able to process the large number of samples from these microplastics projects, with detailed analysis using cutting-edge semi-automated spectroscopic methods, IOW microplastic researchers have constantly been developing and improving methods, both in the sampling and in the processing of samples. Great effort has particularly been focused on the implementation of quality control procedures to improve the accuracy and robustness of results by limiting particle loss as well as contamination, something essential for reliable sampling of very small (i.e. <50µm) microplastics.